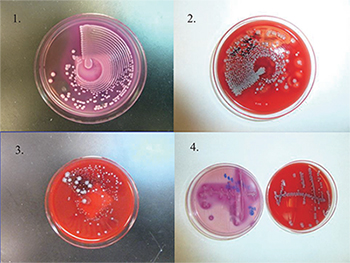
Culture plates (1–3) are streaked by using an automated system (Previ Isola). Fig. 1 is the MacConkey agar plate. Figs. 2 and 3 are the blood agar plate. Fig. 3 is a mixed culture with nice colony separation, which can be used directly for MALDI-TOF MS. For comparison, the culture plate 4 is streaked manually. Photos provided by Yun Wang, MD, PhD.

Anne Paxton
April 2014—Talk to a few microbiology laboratories about why they feel the need to automate and you hear common themes: people, space, quality, and, most of all, time to detection. Microbiology may be late to join the bandwagon, but whether laboratories are making partial or full-scale moves to automate, they are dramatically making up for lost time, in all senses of the phrase. That’s because turnaround time savings are no longer measured in minutes. “Our goal is to be able to give some of these answers out in one to four hours rather than 24 hours, or much longer for some culture-based methods,” says Randall T. Hayden, MD, director of clinical and molecular microbiology at St. Jude Children’s Hospital in Memphis.

Instruments and modules on the market today have added new incentives for microbiology labs to automate at their own pace, says Ann Horning, MT(ASCP)SM, laboratory services manager for microbiology and point-of-care testing at Lancaster (Pa.) General Hospital. “If you look at microbiology two or three years ago, very few automation options were available.” In December, Lancaster General’s microbiology laboratory became the first in the U.S. to install the BD Kiestra InoqulA, delivering automated specimen processing and agar streaking via magnetic bead technology for liquid and non-liquid specimens.
Lancaster’s microbiology laboratory, which has 27 employees, does more than 15,000 tests per month, Horning says, noting that similar-sized area hospital labs in Reading and Harrisburg have also recently decided to automate specimen processing with the InoqulA or Copan Diagnostics WASP: Walk-Away Specimen Processor. “Microbiology labs are moving toward automation because of the focus on staffing and productivity. We can no longer afford to have medical technologists streaking plates.”
She finds that high-quality, standardized specimen inoculation is the biggest impact of the InoqulA. “How agar plates are streaked in the laboratory is variable with each technologist. Having a fixed amount inoculated onto each plate provides better quality outcomes. The staff has embraced this new technology and standardization.”
There has been one drawback, Horning says. “Because we are one of the first in the country to implement the InoqulA, the manuals and procedures that normally are available to us by the manufacturer are not yet available in the U.S. Specimen processing is performed in a biological safety cabinet in the U.S. to avoid infectious disease exposure to the employee. This technology has not yet been incorporated into the semiautomated component of the InoqulA. This is expected to be available by late summer.”
Once the biological safety cabinet is integrated into the InoqulA, the laboratory plans to move toward more around-the-clock plate reading. “Culture reading is performed now on day shift, but this technology will help us expand that to second and third shift.” By late summer, she hopes the laboratory will be performing culture reading 24/7 to improve turnaround time and patient outcomes.
At this point, the laboratory is not planning to reduce staff. “As we decrease staff time on manual plating by using the InoqulA, we have increased our molecular testing platform, so there has been some re-shifting of personnel,” she says.
Given the average age of medical technologists, the laboratory is expecting an outflux of personnel in the next five years, Horning says. “You’re going to want to have more support people to run InoqulA and do the less complex testing, while the medical technologists perform the complex duties. Most automated lines in the laboratory have aimed for staff reduction. This hasn’t yet happened in the microbiology lab, but we are probably heading in that direction.”
In fiscal year 2015, Horning says the laboratory hopes to expand its automation by acquiring the BD Kiestra Work Cell, a software and incubator solution that attaches to InoqulA to move plates in and out of special incubators that include digital imaging. “The one major thing it would impact is patient results in terms of turnaround time and length of stay, which has always been hard to measure. It will take some work to justify the substantial purchase, but hopefully the positive impact will allow us to purchase it.”
How close will that take the laboratory to total automation? “They have other pieces that can be attached, like the Bruker MALDI-TOF mass spectrometer. The Work Cell is a good addition for us as opposed to the TLA [total lab automation] because it will fit into our newly renovated laboratory without any further redesign.”
Meanwhile, some other U.S. laboratories are continuing their march toward total automation. At Evanston Hospital, part of NorthShore University Health System in the northern Chicago suburbs, the laboratory hopes to begin construction in April or May on renovations to prepare for its BD Kiestra TLA system, slated for delivery this summer, says Irene K. Dusich, MT(ASCP)SM, microbiology manager. Once the Illinois public health department has approved final drawings, “we’ll get installed in July, then probably take 90 days to validate it and fix the workflow the way we want it, so we’ll have it up by third quarter.”
With the Kiestra TLA, “the plates go directly from the line into the correct incubator, then they stay there and digital images are taken according to how we program it. Then, should we need to do a workup, the return line will bring the plate to whatever bench needs to work on it.”

Dusich expects to see many things changing once the TLA system is in place, including a new ability for the laboratory to increase testing volume while reducing staff. “Microbiology is typically a day shift department, but a lot of work, especially outreach, comes in on the PM shift. Kiestra will alert us when plates are ready to be read according to how we have programmed the system. After an assessment period of at least six months, I can see us probably going to at least a two-shift operation for plate reading.” The laboratory now has 26 technical FTEs performing the work in microbiology. “We plan to reduce that by five FTEs with the Kiestra, and our hope is that the loss will be by attrition,” Dusich says.
Whether automation is the answer for all sizes of microbiology laboratories is not clear. At St. Jude Children’s in Memphis, for example, the microbiology lab would be considered small to moderate, with a staff of about 25, says Dr. Hayden. But in line with the hospital’s focus on catastrophic pediatric diseases, some of its tests are very high volume. “For example, we might do several hundred viral load tests for something like cytomegalovirus each month, which is comparable to what a very large academic center might do. On the other hand, since we don’t have an emergency room and only see pediatric patients, we do much fewer chlamydia or strep tests.”

The lab automates individual tests when those tests become FDA cleared, but it does not use automation in the broad sense. “We have automated blood cultures, HIV is on an automated system, and we’ll probably be switching to automated testing for CMV viral load. But outside of molecular diagnostics we’re not a very highly automated lab, because for conventional bacteriology our throughput is pretty low,” Dr. Hayden says.
Automation has undeniable advantages in the setting of molecular testing. “If you adopt a sample-to-answer system, many of those will give an answer within an hour or maybe a little more. Some of these cartridge-based systems have limited to no sample prep required. So there may be a few minutes of hands-on tech time, and your turnaround time may drop dramatically. Because you’re not tied to batching, you may be able to give on-demand testing.”
Automation hasn’t reduced the number of staff needed in Dr. Hayden’s laboratory. “If we automate one assay it frees up part of some person’s time to maybe work on another assay. The margin of change in terms of reduced hands-on time isn’t typically enough to bump our staffing requirements downward, particularly given the ever-increasing need for additional tests.” Often labs that implement small-scale automated equipment, such as sample-to-answer PCR, have to pay a fair amount of attention to keeping throughput moving. “You can set up and walk away and it will run for an hour, but if you have four modules and 10 samples and they’re staggered, you’ll have to keep taking things in and out. Depending on how your space and workflow are organized, it might mean you need just as much hands-on time as running a batch system.”
“On the bacteriology side,” Dr. Hayden says, “phenotypic testing involves relatively low-cost systems to begin with when you’re doing manual methodology. There are scaled systems for blood cultures and for automated bacterial ID and susceptibility testing and so forth, but some of the new technologies like MALDI-TOF are priced pretty high and may be harder for smaller labs to cost-justify.” However, because of the number of high-acuity patients at St. Jude, his lab was able to justify a MALDI-TOF and now has the system in validation.
For most labs, space continues to be scarce. “We’re always running out of space. If you are using modular systems and you need two or three or four modules, that takes up a bench position no matter what you do. Some manual methods aren’t ever going away, so basically you are adding on top of what you had before. We have an enormous box for our automated HIV, but we still need our individual cyclers to run LDTs. So I don’t think you can say we’re saving space. The hope is eventually for most systems we won’t need separate extraction, that front-end automated sample preparation will shrink, but at this point it’s just an admixture of systems. No one box does everything.”
To make some of the larger systems cost-effective and to justify taking them through the regulatory process, some manufacturers have targeted mostly high-throughput microbiology labs, Dr. Hayden says. “It’s just a function of how these things have evolved. But I think over time we’ll start to see more overlap and scalability, which will help us and help others.”
More automation is not always a good thing, he emphasizes. “Obviously, you need to ask not only the cost-benefit but also the impact of a new technology in your lab and the impact clinically. Will it work in your practice setting and for your patients and your technical staff? So it’s always a multifactorial decision.”
Comfort levels with new technology may also play a part. “Some labs are very uncomfortable with black-box automation where they can’t see the raw data. If you want a lower-complexity test, you may not want all that data staring at you—you may just want a positive or a negative. But, say for molecular detection, some people like to see an amplification curve for real-time PCR, and if suddenly someone gives you something with just a plus or minus and you can’t really look at the quality of the amplification curve or tell if there are borderline results,” that may not be the best solution for everyone, Dr. Hayden says.

At Grady Health System in Atlanta, one of the largest public health systems in the U.S., the laboratory has been semiautomated for blood cultures and some molecular tests for several years, says Yun F. (Wayne) Wang, MD, PhD, director of microbiology, immunology, and molecular diagnostics. The microbiology laboratory performs tests for the 853-bed hospital and eight community clinics.
In 2011, in addition to the existing BacT/Alert 3D blood culture system, Etest, Vitek 2, Vidas, and MicroScan systems used in the clinical microbiology lab, other automation was acquired: bioMérieux’s Previ Isola plating device (“the 100th in the world,” Dr. Wang says), the Previ Color Gram, and the MALDI-TOF Vitek MS (“the first mass spectrometer from bioMérieux purchased and installed in North America”). “These components are getting us ready for full automation,” says Dr. Wang, associate professor of pathology and laboratory medicine at Emory University School of Medicine.
He sees the hospital’s Beckman system for performing chemistry and immunology as a model track system to which the microbiology laboratory can aspire. His experience with molecular automated systems such as the Tigris DTS System for sexually transmitted infections and HPV testing, as well as the m2000 RealTime System for HIV and HCV testing, suggest they’ll be helpful in leading the conventional clinical microbiology lab to automation. “To me, if you compare microbiology to the Beckman system, we’re still not there yet. Right now we have years to go before TLA from beginning to end. But we are on our way.”

With a modular, piecemeal approach to automation, calculating a return on investment is not necessarily easy, he says. “Automated plating is going to save the technologist time just for plating, but also with manual plating it actually takes more time to process and identify the organisms or pathogens. If you have a mix of cultures, some of the organisms may be normal flora and some pathogens. When I first came, the pressure was always to subculture, subculture, subculture, work out identification, and just keep trying to isolate cultures. You would waste a day doing that to get quick identifications because you always felt some colonies are big, some are small.”

By contrast, “Automation gives you a very clear, clean isolation of each colony, so in that way it saves real work on the part of the technologist. Using mass spectrometry as well, you don’t need a large number of colonies or cultures. If you have a single one, if it’s very clean, you can analyze that in the patient.”
The integration of bioMerieux’s BacT/Alert, Vitek 2, Vitek MS, and Myla has helped his laboratory significantly reduce the time for positive identification of infectious organisms and antimicrobial susceptibility testing, Dr. Wang says. In his research, “we have seen reductions in time to results from as long as two days down to hours or even minutes once the culture turns positive.”
When the clinicians do infectious disease laboratory rounds and give medical students a tour of the microbiology laboratory, the perfect streaking that the specimen processor can do compared with manual streaking is always something to show off. “But that’s not the main reason we want to have the automation,” Dr. Wang says. “The clinicians know that with the MALDI-TOF, we are able to show them identification of results much more quickly. And that’s not just for bacteria but also for yeast, which used to grow much more slowly—it might take two or three days for a tiny, tiny culture. But the MALDI-TOF has changed the whole concept. We can now identify the organism right away, and that’s especially important for us, because we also have multiple drug-resistant organisms such as Acinetobacter baumannii to worry about.”
Given the FDA’s approval of automated instruments for microbiology, a majority of midsize and large laboratories stand to benefit, he says. “I think it is much easier than before for the hospital to capture the savings it needs from acquiring this equipment. The facility can really utilize it so it doesn’t need to rely on a lot of technologists on one shift, and personnel without a lot of expertise in the evening or weekend shift can handle it.” The more people get to know the technology and see how it works, he says, the easier it will be to foresee the potential benefits.
Automation is proving to be a winner for a completely different type of operation: Alverno Clinical Laboratories, a central laboratory facility in Hammond, Ind., that is jointly owned by hospitals in Indiana and Illinois. Microbiology for the 26 hospitals in the network gets physically shipped through couriers running up to four times a day to Hammond, from sites 15 minutes to three hours away. Although the centralized services microbiology model has been extremely successful, increasing automation has also led to significant changes.
“Traditionally,” says central laboratory director Dale R. Kahn, MT(ASCP), “the individual hospitals would plate and incubate their own microbiology tests, and the couriers used an incubated transport system so the cultures continued to grow during transport.” Two years ago, Alverno started to look at automation because it saw dramatic growth in its outreach business even while it was getting more and more difficult to find technologists. With predicted growth, Alverno knew it would need to add more bench space, but there were physical constraints. “We needed to adapt to accommodate increased volume,” explains Jim Clark, BS, SM(ASCP), manager of the microbiology laboratory.
“We looked at it in three phases. The first was automating our setups. So we went out in the market, looked at vendors, and chose Copan’s WASP.” Alverno acquired two units and went live in February 2013. “The workflow process allows our hospitals to send specimens directly to the central laboratory and the robotic instrument plates the specimens.”
The second phase was the instrumentation for rapid identifications. The Bruker MALDI-TOF was installed in 2013. “This decision was partly because they had a benchtop model that didn’t take up floor space. It was very conducive to any space limitations,” Clark says. “The big thing with the Bruker was that it reduced our turnaround time for IDs to such a degree that whereas conventional systems took anywhere from six to 24 hours, now we could get an ID out in a few minutes.”
Almost immediately, Alverno started to get calls from pharmacists and infectious disease doctors saying they were seeing an immediate impact on patients from getting them off antivirals and the broad-spectrum antibiotics earlier, and from shortening length of stay.
The third phase was bringing in a robotic track and the smart incubators. “That just came March 17,” Kahn says, “and when we finish the installation, we will be the first laboratory in the U.S. to implement this Copan technology and have total automation for microbiology.”
Kahn predicts the installation will revolutionize the way the laboratory works. “Today, when we do a workup, it is typically in a kind of semi-batch. At certain times, the technologists pull plates out of the incubators and take them to the benches and work up the cultures. But once we are underway, the plates will proceed from the automated specimen processor down the conveyor belt, a high-resolution camera will take a picture, and then a robotic arm will place them into the incubator. Since the plate will stay in the incubator most of the time, versus coming in and out as it does today, that will reduce turnaround time.”
Clark and Kahn believe the identifications will be sharply faster with the new system, and they expect that the validations being conducted now will bear that out before the laboratory goes live with patient samples. “Because we are the first site in the U.S., there is obviously a lot more work to be done. But under our timeline, the validations will be done in less than three months, and we can go to full implementation,” Clark says.
Instead of the technologists looking at a plate, the smart incubator will take those plates back to the camera at specified intervals, depending on the culture type under each different protocol. “The techs in the future will look at computer screens rather than plates,” he says. “The advantage is that Copan can automatically segregate them semiquantitatively from heaviest growth to no growths. The tech can very quickly look on the computer screen, see which is which, and report it. Then the robot knows to retrieve those plates, send them down the conveyor belt, and dump them into the garbage if there is no growth. A tech can then quickly drop information into the LIS, or ID the colony on the MALDI, or do a susceptibility on the MicroScan or a Gram stain or subculture or whatever. It just involves a click on a computer screen.”
With the new system’s cameras, photos can be taken at six or 12 hours or at whatever interval is ordered. A dashboard on the wall will display the number of plates ready to be screened, retrieved, or read to identify. “It will even tell you at 2 pm this afternoon it’s going to have this many plates ready to be read. So instead of batch mode like traditional microbiology, we will be active round the clock.” It will shave time and make the operation more efficient, he adds.
The two incubators the laboratory now has each hold 1,764 plates and can handle about half of the laboratory’s volume, which is about 2,000 plated cultures a day, Clark says. “You’re holding some plates for more than one day—even four days for a slow-growing organism—so that’s why you need space for a large number of plates.” But with the automation, “I would anticipate we can handle our projected growth with no problem. We calculate we could absorb 30 percent to 50 percent growth without any additional FTEs.”
“The nice thing about this system,” Clark says, “is that as long as there is space to add an incubator and piece of connecting track, and if necessary another front-end instrument for all the plated cultures, that’s really all that’s needed. By reading plates on a computer, you save two-thirds of your bench space that’s needed to work on cultures. You don’t need to put plates on your counter to shuffle them back and forth into the incubator.” Instead, it’s your computer screen, mouse, and computer. “The only workup area is the centralized one near the end of the track.”
Alverno has an additional improvement project involving blood culture centralization and rapid identifications. The laboratory just completed its validation protocols for centralizing all blood cultures at the central lab.
“Under the old method,” Kahn says, “each hospital would do its blood cultures on site, and if they went five days and stayed negative the whole time, they would final them out. If they were positive, they would do a Gram stain and subculture the specimen and send it to the central lab to work it up. In the near future, the blood culture bottle will be immediately available to perform an extraction, put it on our MALDI, and get an ID in only half an hour. Once we centralize the cabinets for the more critical sepsis patients, we can actually get the ID almost a day earlier than before. So it will be huge for patient care.”
The aim, on behalf of the hospitals, is to decrease turnaround time via automation, Clark says. “With the increase in constraints on everybody in the health care system, it’s increasingly difficult to maintain the level of service expected in the hospitals to plate cultures 24/7. If you have a midnight-shift hospital of 200 beds with only one or two people in the laboratory, those specimens may sit for almost an entire shift before there’s an opportunity to plate them and get them going. In those cases you transport to the central lab, and you connect to our more swift automated process.”
Clark, a microbiologist for 40 years, says it’s exciting to change the way the laboratory operates. “Switching over to essentially a continuous process rather than batch processing is something that is needed. But doing it without automation and computers and robotics would require an increase of personnel and staff management as well as sorting of cultures into slots and racks.”
The benefits in terms of staff time have already been seen in the centralized laboratory and in reduced FTEs at the hospital sites, Kahn says. “My advice for every microbiology laboratory in the country: It’s a must to adopt automation, especially rapid identification, whether they do the MALDI or molecular technology. Whether it’s all of what we did or pieces of what we did, every microbiology laboratory needs to consider microbiology automation to deliver better patient care.”
[hr]
Anne Paxton is a writer in Seattle.